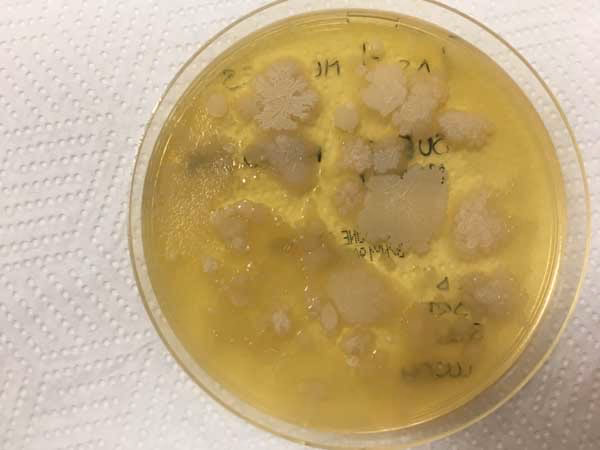

29/01/2024
El mundo que nos rodea está habitado por una diversidad asombrosa de vida, gran parte de ella invisible a simple vista. Entre estos habitantes microscópicos se encuentran las bacterias, organismos fascinantes que desempeñan roles cruciales en casi todos los ecosistemas del planeta, incluyendo nuestro propio cuerpo. Para los estudiantes, tener la oportunidad de observar y estudiar estos microorganismos de cerca puede ser una experiencia educativa increíblemente enriquecedora. El cultivo de bacterias en un entorno escolar permite comprender mejor la microbiología, siempre y cuando se sigan estrictos protocolos de seguridad.
Antes de adentrarnos en las técnicas de cultivo, es fundamental comprender qué son exactamente las bacterias. A nivel de educación secundaria, podemos definirlas como organismos unicelulares procariotas. Esto significa que son células individuales que carecen de un núcleo definido y otros orgánulos complejos unidos por membranas. Se encuentran prácticamente en todas partes: en el suelo, el agua, el aire, e incluso en y sobre nuestro cuerpo. La mayoría de las bacterias que habitan en los seres humanos son inofensivas o incluso beneficiosas, ayudando en procesos como la digestión. Sin embargo, una pequeña proporción de especies bacterianas son patógenas, es decir, pueden causar enfermedades.

Un cultivo bacteriano es, esencialmente, una técnica de laboratorio que permite hacer crecer y multiplicar bacterias en un medio controlado. Esto se hace para poder estudiar sus características, identificarlas o probar cómo reaccionan a ciertas sustancias, como los antibióticos. Es una herramienta fundamental tanto en la investigación científica como en aplicaciones prácticas, como la producción de alimentos y medicamentos, y especialmente en el diagnóstico médico para identificar la causa de infecciones.
El Cultivo de Bacterias en el Laboratorio Escolar
Llevar a cabo un cultivo bacteriano en un laboratorio escolar es una actividad que requiere planificación y, sobre todo, un enfoque riguroso en la seguridad. El objetivo es observar el crecimiento microbiano sin el riesgo de cultivar patógenos humanos peligrosos. Para ello, se siguen pasos específicos una vez que se ha recolectado una muestra (inoculación) y se ha colocado en una placa de Petri con un medio de cultivo adecuado (generalmente agar).
El primer paso crucial tras la inoculación es asegurar la tapa de la placa de Petri. Por razones de seguridad, la tapa debe fijarse firmemente en su lugar utilizando tiras de cinta adhesiva. Esto evita que la placa se abra accidentalmente y que los microorganismos cultivados se dispersen en el ambiente. Una vez sellada, la placa debe ser etiquetada claramente con la fecha de la inoculación y cualquier otra información relevante, como el tipo de muestra o el nombre del estudiante o grupo responsable.
La incubación es el proceso donde se proporcionan las condiciones óptimas para que las bacterias crezcan. En los laboratorios escolares, las placas de agar inoculadas se incuban típicamente a una temperatura de 25°C. Esta temperatura es significativamente más baja que la temperatura corporal humana (37°C). La razón de esto es fundamental para la seguridad: incubar a 25°C fomenta el crecimiento de muchas bacterias ambientales comunes que generalmente no son patógenas para los humanos, mientras que inhibe o ralentiza significativamente el crecimiento de la mayoría de los patógenos humanos, que están adaptados a prosperar a 37°C. El tiempo de incubación también es limitado, generalmente no más de 24 a 48 horas. Esto permite observar el crecimiento de colonias bacterianas antes de que alcancen densidades que podrían aumentar el riesgo.
Técnicas de Cultivo Bacteriano: Un Vistazo Profesional
Si bien el cultivo en el aula se enfoca en principios generales y seguridad, los laboratorios profesionales utilizan diversas técnicas de cultivo bacteriano con propósitos diagnósticos y de investigación. Comprender estas técnicas ayuda a dimensionar la importancia de la microbiología y los cultivos en el mundo real. Todos estos métodos buscan aislar e identificar bacterias que podrían estar causando una infección.
Existen varios tipos de cultivos utilizados comúnmente en entornos clínicos:
Cultivo de Garganta
Este es uno de los cultivos más conocidos. Un profesional de la salud utiliza un hisopo especial para tomar una muestra de la parte posterior de la garganta y las amígdalas del paciente. El objetivo principal suele ser diagnosticar o descartar una infección causada por la bacteria Streptococcus pyogenes, responsable de la faringitis estreptocócica (amigdalitis) y otras enfermedades como la escarlatina o incluso la fascitis necrosante en casos raros y graves.
Cultivo de Orina
Para esta prueba, se solicita al paciente que recoja una muestra de orina en un recipiente estéril, siguiendo instrucciones precisas para evitar la contaminación. El cultivo de orina es fundamental para detectar infecciones del tracto urinario (ITU), que pueden afectar los riñones, la vejiga, los uréteres o la uretra. La prueba no solo confirma la presencia de bacterias, sino que también ayuda a identificar la especie específica causante de la infección, lo cual es crucial para seleccionar el antibiótico adecuado.
Cultivo de Esputo
El esputo es la mucosidad espesa que se produce en los pulmones y las vías respiratorias bajas, a menudo expulsada al toser. Obtener una muestra adecuada puede ser un desafío. A veces, el paciente puede producir la muestra tosiendo profundamente, pero en otros casos, puede ser necesario un procedimiento como una broncoscopia, donde se inserta un tubo flexible en las vías respiratorias para recolectar la muestra. Este cultivo es vital para diagnosticar infecciones bacterianas en los pulmones y bronquios, como neumonía o tuberculosis.
Cultivo de Sangre
Este cultivo se realiza tomando una muestra de sangre, generalmente de una vena en el brazo. Es una prueba crítica cuando se sospecha una infección sistémica, donde las bacterias (o a veces hongos) han entrado en el torrente sanguíneo, una condición conocida como bacteriemia o septicemia, que puede ser potencialmente mortal. El cultivo de sangre permite identificar el microorganismo presente y determinar su sensibilidad a los antibióticos.
Cultivo de Heces
Para este cultivo, el paciente debe proporcionar una muestra de heces en un recipiente limpio. Se utiliza para identificar bacterias patógenas en el sistema digestivo que pueden causar diarrea, intoxicaciones alimentarias u otras enfermedades gastrointestinales. A menudo, este cultivo se combina con pruebas para detectar virus o parásitos, ya que los síntomas digestivos pueden tener diversas causas.
Cultivo de una Herida
Cuando una herida, quemadura o lesión en la piel muestra signos de infección (enrojecimiento, hinchazón, pus, dolor), se puede realizar un cultivo de la herida. El médico utiliza un hisopo para recoger una muestra de la superficie de la herida o del pus. En el caso de heridas profundas o abscesos, puede ser necesario aspirar líquido con una jeringa o incluso tomar una biopsia de tejido. Este cultivo identifica las bacterias presentes y ayuda a guiar el tratamiento con antibióticos.
Tabla Comparativa de Cultivos Clínicos
Para visualizar mejor los diferentes tipos de cultivos clínicos mencionados y sus aplicaciones:
| Tipo de Cultivo | Muestra Típica | Infecciones Detectadas Comúnmente |
|---|---|---|
| Garganta | Hisopo faríngeo/amigdalar | Faringitis por Estreptococo, Escarlatina |
| Orina | Orina estéril | Infecciones del tracto urinario (ITU) |
| Esputo | Mucosa pulmonar | Neumonía, Tuberculosis, Bronquitis bacteriana |
| Sangre | Sangre venosa | Bacteriemia, Sepsis, Fungemia |
| Heces | Muestra fecal | Infecciones gastrointestinales bacterianas (ej. Salmonella, E. coli patógena) |
| Herida | Hisopo de exudado, pus, tejido | Infecciones de piel y tejidos blandos, infecciones de quemaduras |
Consideraciones de Seguridad Cruciales en el Aula
Volviendo al entorno escolar, no podemos enfatizar lo suficiente la importancia de la seguridad. Además de la temperatura de incubación de 25°C y la limitación del tiempo, la esterilización es un paso final absolutamente crítico. Después de observar los resultados del cultivo, las placas de Petri y cualquier otro equipo que haya estado en contacto con los cultivos deben ser esterilizados. Esto generalmente se logra mediante un proceso de autoclave (calor y presión elevados) o sumergiendo las placas en una solución desinfectante fuerte durante un tiempo adecuado. El objetivo es matar todas las bacterias cultivadas antes de desechar el material para evitar cualquier riesgo de propagación de microorganismos. Nunca se deben abrir las placas una vez que se ha observado crecimiento.
Preguntas Frecuentes sobre el Cultivo Bacteriano Escolar
- ¿Por qué se incuba a 25°C en la escuela y no a 37°C?
- Se incuba a 25°C para fomentar el crecimiento de bacterias ambientales comunes y seguras, mientras se minimiza el riesgo de que crezcan bacterias patógenas humanas, que prefieren la temperatura corporal de 37°C.
- ¿Es peligroso cultivar bacterias en el aula?
- Si se siguen estrictamente los protocolos de seguridad, como la incubación a 25°C, el sellado de las placas y la esterilización posterior, el riesgo es mínimo. La clave está en prevenir el crecimiento de patógenos y manejar los cultivos de forma segura.
- ¿Qué se hace con las placas de cultivo después de usarlas?
- Las placas, una vez observadas, deben ser esterilizadas para matar todos los microorganismos antes de ser desechadas. Esto se realiza mediante autoclave o desinfección química, según los recursos del laboratorio.
- ¿Cuánto tiempo se tarda en ver el crecimiento bacteriano?
- El crecimiento visible de colonias bacterianas generalmente se observa dentro de las 24 a 48 horas de incubación a 25°C, dependiendo del tipo de bacteria y la densidad inicial en la muestra.
- ¿Se pueden identificar las bacterias cultivadas a simple vista?
- A simple vista, solo se pueden ver las colonias (grupos de millones de bacterias). Para identificar el tipo específico de bacteria, se necesitarían técnicas microscópicas y bioquímicas más avanzadas que suelen realizarse en laboratorios profesionales.
El estudio de las bacterias a través de su cultivo en el laboratorio escolar ofrece una ventana fascinante al mundo microscópico. Es una oportunidad invaluable para que los estudiantes aprendan sobre la vida microbiana, la importancia de la higiene y la bioseguridad, y los fundamentos de la microbiología. Al seguir cuidadosamente los procedimientos y priorizar siempre la seguridad, esta actividad puede ser una experiencia educativa memorable y segura que despierte el interés por la ciencia.
Si quieres conocer otros artículos parecidos a Cultivo de Bacterias en la Escuela: Guía Segura puedes visitar la categoría Educación.
